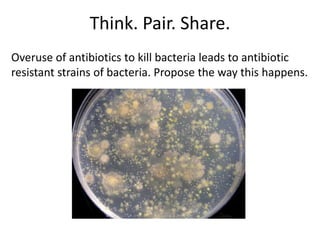
Think. Pair. Share.
Overuse of antibiotics to kill bacteria leads to antibiotic
resistant strains of bacteria. Propose the way this happens.

Genetic variation within species occurs due to mutations. Mutations can happen in somatic cells or germ cells. Germ cell mutations are passed to offspring and can create new variations within a population. Mutations may be harmful, neutral, or beneficial to an organism's survival and ability to reproduce. Beneficial mutations are more likely to proliferate in future generations as those organisms have a selective advantage. This leads to the adaptation of a species over time through natural selection.